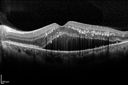
MA_HTN_thne_07.jpg
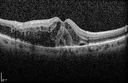
MA_selfsealed_loko_04.jpg
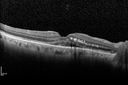
ma_doba1_120314_07.jpg

Most viewed - Macroaneurysm
|

coats disease; exudative retinitis; retinal telangiectasis; leber multiple miliary aneurysm disease1783 viewsclassic coats
|
|

Retinal Arterial Macroaneurysm - Recurrent Hemorrhage 6 months post laser1638 views6 months post laser: Her vision had improved, but then three weeks ago it worsened again. She is not on any blood thinners. She wasn’t doing any heavy lifting or straining.
VISUAL ACUITY: OD 3/200
|
|

Ruptured Retinal Arterial Macroaneurysm - Submacular Hemorrhage - Vision 20/400 never recovered - Hypertension 205/941176 views
|
|

Retinal Arterial Macroaneurysm - Normal Vision (2 Years before rupture)1110 views78-year-old woman has a retinal arterial macroaneurysm in the right eye. VA 20/25 (pre-rupture photos)
|
|

Ruptured Retinal Arterial Macroaneurysm - Submacular Hemorrhage - Vision 20/400 never recovered - Hypertension 205/941104 views
|
|

Macroaneurysm FP1068 viewsMacroaneurysm with Subretinal Hemorrhage and ME in OS of an Elderly Female
|
|

Ruptured Retinal Arterial Macroaneurysm - Submacular Hemorrhage - Vision 20/400 never recovered - Hypertension 205/94958 views
|
|

Retinal Arterial Macroaneurysm - Increased Swelling after Laser 944 views65-year-old woman was seen in the office on January 12, 2011. She has noticed decreased vision in the right eye for the last two or three weeks. She has had some discomfort in both eyes as well. She has a history of low blood pressure, but she does have high cholesterol.
VISUAL ACUITY: OD 20/60
|
|

Ruptured Retinal Arterial Macroaneurysm - Submacular Hemorrhage - Vision 20/400 never recovered - Hypertension 205/94936 views
|
|

Retinal Arterial Macroaneurysm - Normal Vision (2 Years before rupture)896 views78-year-old woman has a retinal arterial macroaneurysm in the right eye. VA 20/25 (pre-rupture photos)
|
|

Ruptured Retinal Arterial Macroaneurysm - Submacular Hemorrhage - Vision 20/400 never recovered - Hypertension 205/94841 views
|
|

Retinal Arterial Macroaneurysm - Increased Swelling after Laser 830 views65-year-old woman was seen in the office on January 12, 2011. She has noticed decreased vision in the right eye for the last two or three weeks. She has had some discomfort in both eyes as well. She has a history of low blood pressure, but she does have high cholesterol.
VISUAL ACUITY: OD 20/60
|
|

Retinal Arterial Macroaneurysm - Ruptured and self Sealed - Vision Back to 20/80 after 6 Months828 views81-year-old woman vision improving 6 months following rupture of retinal arterial macroaneurysm. Vision OD is 20/80
|
|

Retinal Arterial Macroaneurysm - Increased Swelling after Laser 817 viewsVisit 3 - 4 months post laser:
on May 23, 2011. This pleasant 66-year-old woman had a leaky arterial macroaneurysm I lasered in January. She developed more swelling subsequently, but an angiogram showed the lesion was closed. Since then she has noticed her vision poor in the eye.
VISUAL ACUITY: OD 20/200
|
|

Retinal Arterial Macroaneurysm - Increased Swelling after Laser 814 views65-year-old woman was seen in the office on January 12, 2011. She has noticed decreased vision in the right eye for the last two or three weeks. She has had some discomfort in both eyes as well. She has a history of low blood pressure, but she does have high cholesterol.
VISUAL ACUITY: OD 20/60
|
|

Retinal Arterial Macroaneurysm - Recurrent Hemorrhage 6 months post laser785 views6 months post laser: Her vision had improved, but then three weeks ago it worsened again. She is not on any blood thinners. She wasn’t doing any heavy lifting or straining.
VISUAL ACUITY: OD 3/200
|
|

Retinal Arterial Macroaneurysm - Ruptured - Vitreous Hemorrhage (Fresh) 5/200 Vision782 views80-year-old woman has a retinal arterial macroaneurysm in the right eye I saw two years ago. She noticed the sudden onset of vision loss last night. OD is 5/200.
|
|

Retinal Arterial Macroaneurysm - Normal Vision (2 Years before rupture)781 views78-year-old woman has a retinal arterial macroaneurysm in the right eye. VA 20/25 (pre-rupture photos)
|
|

periphery 3. od769 viewsleaking miliary aneurysms
|
|

Retinal Arterial Macroaneurysm - Untreated Hypertension (250/135) - Serous Macular Detachment769 views82 year old asian woman. VA 20/80 Headaches and vision loss for 1 month. Negative medical history but has not been to the doctor for years. (no insurance)
|
|

Ruptured Retinal Arterial Macroaneurysm - Submacular Hemorrhage - Vision 20/400 never recovered - Hypertension 205/94765 views
|
|

Ruptured Retinal Arterial Macroaneurysm - Submacular Hemorrhage - Vision 20/400 never recovered - Hypertension 205/94745 views
|
|

Retinal Arterial Macroaneurysm - Ruptured - Vitreous Hemorrhage (Fresh) 5/200 Vision737 views80-year-old woman has a retinal arterial macroaneurysm in the right eye I saw two years ago. She noticed the sudden onset of vision loss last night. OD is 5/200.
|
|

Ruptured Retinal Arterial Macroaneurysm - Submacular Hemorrhage - Vision 20/400 never recovered - Hypertension 205/94735 views
|
|

macula. od727 viewscoalescing exudates
|
|

Retinal Arterial Macroaneurysm - Ruptured - Vitreous Hemorrhage (Fresh) 5/200 Vision705 views80-year-old woman has a retinal arterial macroaneurysm in the right eye I saw two years ago. She noticed the sudden onset of vision loss last night. OD is 5/200.
|
|

oct superior macula 1. od696 views
|
|

periphery 1. od 694 viewsquiescient/infarcted macroaneurysm
|
|

Retinal Arterial Macroaneurysm - Ruptured and self-sealed after hemorrhage693 views90-year-old woman has vision loss in the right eye for 6 weeks. OD 8/200, OS 20/50. Initial Visit
|
|

Retinal Arterial Macroaneurysm - Ruptured and self-sealed after hemorrhage685 views90-year-old woman has vision loss in the right eye for 6 weeks. OD 8/200, OS 20/50. Initial Visit
|
|

Retinal Arterial Macroaneurysm - Increased Swelling after Laser 683 viewsVisit 2 - 2 months later:
March 21, 2011. This pleasant 66-year-old woman had laser to retinal arterial microaneurysm in the right eye January 12th. Her vision was getting better, but now it is worse the last few days. She is at home taking care of her demented mother and she and her sister lift her mother a fare amount of the time. I also checked her blood pressure, which was 120/65. VISUAL ACUITY: OD 20/200
|
|

Retinal Arterial Macroaneurysm - Boat Shaped Hemorrhage674 views93 year old woman getting every 2 months Lucentis injection for wet AMD developed a ruptured MA. No treatment was done and the vision improved
|
|

Ruptured Retinal Arterial Macroaneurysm - Submacular Hemorrhage - Vision 20/400 never recovered - Hypertension 205/94668 views
|
|

Retinal Arterial Macroaneurysm - Untreated Hypertension (250/135) - Serous Macular Detachment 662 views82 year old asian woman. VA 20/80 Headaches and vision loss for 1 month. Negative medical history but has not been to the doctor for years. (no insurance)
|
|

Retinal Arterial Macroaneurysm - Ruptured and self-sealed after hemorrhage655 views90-year-old woman has vision loss in the right eye for 6 weeks. OD 8/200, OS 20/50. Initial Visit
|
|

Retinal Arterial Macroaneurysm - Increased Swelling after Laser 654 viewsVisit 2 - 2 months later:
March 21, 2011. This pleasant 66-year-old woman had laser to retinal arterial microaneurysm in the right eye January 12th. Her vision was getting better, but now it is worse the last few days. She is at home taking care of her demented mother and she and her sister lift her mother a fare amount of the time. I also checked her blood pressure, which was 120/65. VISUAL ACUITY: OD 20/200
|
|

Retinal Arterial Macroaneurysm - Ruptured and self-sealed after hemorrhage653 views90-year-old woman has vision loss in the right eye for 6 weeks. OD 8/200, OS 20/50. Initial Visit
|
|

Retinal Arterial Macroaneurysm - Increased Swelling after Laser 649 views65-year-old woman was seen in the office on January 12, 2011. She has noticed decreased vision in the right eye for the last two or three weeks. She has had some discomfort in both eyes as well. She has a history of low blood pressure, but she does have high cholesterol.
VISUAL ACUITY: OD 20/60
|
|

Self Sealed Retinal Arteriol Macroaneurysm 639 viewsFA on presentation showed minimal to no active leakage. Also, there is a small cuff of blood around the MA which is favorable for closure
|
|

Retinal Arterial Macroaneurysm - Increased Swelling after Laser 635 views65-year-old woman was seen in the office on January 12, 2011. She has noticed decreased vision in the right eye for the last two or three weeks. She has had some discomfort in both eyes as well. She has a history of low blood pressure, but she does have high cholesterol.
VISUAL ACUITY: OD 20/60
|
|

Retinal Arterial Macroaneurysm - Increased Swelling after Laser 634 views65-year-old woman was seen in the office on January 12, 2011. She has noticed decreased vision in the right eye for the last two or three weeks. She has had some discomfort in both eyes as well. She has a history of low blood pressure, but she does have high cholesterol.
VISUAL ACUITY: OD 20/60
|
|

Retinal Arterial Macroaneurysm - Increased Swelling after Laser 633 views65-year-old woman was seen in the office on January 12, 2011. She has noticed decreased vision in the right eye for the last two or three weeks. She has had some discomfort in both eyes as well. She has a history of low blood pressure, but she does have high cholesterol.
VISUAL ACUITY: OD 20/60
|
|

Retinal Arterial Macroaneurysm - Increased Swelling after Laser 631 viewsVisit 2 - 2 months later:
March 21, 2011. This pleasant 66-year-old woman had laser to retinal arterial microaneurysm in the right eye January 12th. Her vision was getting better, but now it is worse the last few days. She is at home taking care of her demented mother and she and her sister lift her mother a fare amount of the time. I also checked her blood pressure, which was 120/65. VISUAL ACUITY: OD 20/200
|
|

oct fovea. od628 views
|
|

montage. os626 viewsno disease
|
|

Macroaneurysm FA620 viewsMacroaneurysm with Subretinal Hemorrhage and ME in OS of an Elderly Female
|
|

Retinal Arterial Macroaneurysm - Increased Swelling after Laser 614 viewsVisit 2 - 2 months later:
March 21, 2011. This pleasant 66-year-old woman had laser to retinal arterial microaneurysm in the right eye January 12th. Her vision was getting better, but now it is worse the last few days. She is at home taking care of her demented mother and she and her sister lift her mother a fare amount of the time. I also checked her blood pressure, which was 120/65. VISUAL ACUITY: OD 20/200
|
|

Retinal Arterial Macroaneurysm - Increased Swelling after Laser 612 viewsVisit 2 - 2 months later:
March 21, 2011. This pleasant 66-year-old woman had laser to retinal arterial microaneurysm in the right eye January 12th. Her vision was getting better, but now it is worse the last few days. She is at home taking care of her demented mother and she and her sister lift her mother a fare amount of the time. I also checked her blood pressure, which was 120/65. VISUAL ACUITY: OD 20/200
|
|

Retinal Arterial Macroaneurysm - Untreated Hypertension (250/135) - Serous Macular Detachment607 views82 year old asian woman. VA 20/80 Headaches and vision loss for 1 month. Negative medical history but has not been to the doctor for years. (no insurance)
|
|

periphery 2. od603 viewsleaking miliary aneurysms
|
|

Ruptured Retinal Arterial Macroaneurysm - Submacular Hemorrhage - Vision 20/400 never recovered - Hypertension 205/94599 views
|
|

autofluorescence. od599 viewsautofluorescence helps localize the subretiinal fluid
|
|

Retinal Arterial Macroaneurysm - Increased Swelling after Laser 594 views65-year-old woman was seen in the office on January 12, 2011. She has noticed decreased vision in the right eye for the last two or three weeks. She has had some discomfort in both eyes as well. She has a history of low blood pressure, but she does have high cholesterol.
VISUAL ACUITY: OD 20/60
|
|

oct superior macula 2. od592 views
|
|

wide angle fa late. od591 viewsleaking vessels
|
|

Retinal Arterial Macroaneurysm - Increased Swelling after Laser 585 views65-year-old woman was seen in the office on January 12, 2011. She has noticed decreased vision in the right eye for the last two or three weeks. She has had some discomfort in both eyes as well. She has a history of low blood pressure, but she does have high cholesterol.
VISUAL ACUITY: OD 20/60
|
|

Retinal Arterial Macroaneurysm - Increased Swelling after Laser 580 viewsVisit 2 - 2 months later:
March 21, 2011. This pleasant 66-year-old woman had laser to retinal arterial microaneurysm in the right eye January 12th. Her vision was getting better, but now it is worse the last few days. She is at home taking care of her demented mother and she and her sister lift her mother a fare amount of the time. I also checked her blood pressure, which was 120/65. VISUAL ACUITY: OD 20/200
|
|

Retinal Arterial Macroaneurysm - Ruptured and self-sealed after hemorrhage568 views6 Month Follow-up
91-year-old woman had a retinal arterial macroaneurysm in the right eye 6 Month Follow-up Vision is 20/200.
|
|

Retinal Arterial Macroaneurysm - Untreated Hypertension (250/135) - Serous Macular Detachment568 views82 year old asian woman. VA 20/80 Headaches and vision loss for 1 month. Negative medical history but has not been to the doctor for years. (no insurance)
|
|
Retinal Arterial Macroaneurysm - Untreated Hypertension (250/135) - Serous Macular Detachment567 views82 year old asian woman. VA 20/80 Headaches and vision loss for 1 month. Negative medical history but has not been to the doctor for years. (no insurance)
|
|

Ruptured Retinal Arterial Macroaneurysm - Submacular Hemorrhage - Vision 20/400 never recovered - Hypertension 205/94565 views
|
|

Retinal Arterial Macroaneurysm - Untreated Hypertension (250/135) - Serous Macular Detachment564 views82 year old asian woman. VA 20/80 Headaches and vision loss for 1 month. Negative medical history but has not been to the doctor for years. (no insurance)
|
|

Retinal Arterial Macroaneurysm - Ruptured and self-sealed after hemorrhage561 views6 Month Follow-up
91-year-old woman had a retinal arterial macroaneurysm in the right eye 6 Month Follow-up Vision is 20/200.
|
|

Retinal Arterial Macroaneurysm - Untreated Hypertension (250/135) - Serous Macular Detachment559 views82 year old asian woman. VA 20/80 Headaches and vision loss for 1 month. Negative medical history but has not been to the doctor for years. (no insurance)
|
|

Ruptured Retinal Arterial Macroaneurysm - Submacular Hemorrhage - Vision 20/400 never recovered - Hypertension 205/94557 views
|
|

Retinal Arterial Macroaneurysm - Increased Swelling after Laser 555 views65-year-old woman was seen in the office on January 12, 2011. She has noticed decreased vision in the right eye for the last two or three weeks. She has had some discomfort in both eyes as well. She has a history of low blood pressure, but she does have high cholesterol.
VISUAL ACUITY: OD 20/60
|
|

Retinal Arterial Macroaneurysm - Ruptured and self-sealed after hemorrhage553 views6 Month Follow-up
91-year-old woman had a retinal arterial macroaneurysm in the right eye 6 Month Follow-up Vision is 20/200.
|
|

Ruptured Retinal Arterial Macroaneurysm - Submacular Hemorrhage - Vision 20/400 never recovered - Hypertension 205/94543 views
|
|

wide angle fa mid. od538 viewsleaking, abnormal vessels
|
|

Ruptured Retinal Arterial Macroaneurysm - Submacular Hemorrhage - Vision 20/400 never recovered - Hypertension 205/94536 views
|
|

Ruptured Retinal Arterial Macroaneurysm - Submacular Hemorrhage - Vision 20/400 never recovered - Hypertension 205/94533 views
|
|

Retinal Arterial Macroaneurysm - Ruptured and self-sealed after hemorrhage528 views90-year-old woman has vision loss in the right eye for 6 weeks. OD 8/200, OS 20/50. Initial Visit
|
|

Retinal Arterial Macroaneurysm - Untreated Hypertension (250/135) - Serous Macular Detachment524 views82 year old asian woman. VA 20/80 Headaches and vision loss for 1 month. Negative medical history but has not been to the doctor for years. (no insurance)
|
|

Retinal Arterial Macroaneurysm - Ruptured and self-sealed after hemorrhage522 views90-year-old woman has vision loss in the right eye for 6 weeks. OD 8/200, OS 20/50. Initial Visit
|
|

Ruptured Retinal Arterial Macroaneurysm - Submacular Hemorrhage - Vision 20/400 never recovered - Hypertension 205/94520 views
|
|

Retinal Arterial Macroaneurysm - Increased Swelling after Laser 520 views65-year-old woman was seen in the office on January 12, 2011. She has noticed decreased vision in the right eye for the last two or three weeks. She has had some discomfort in both eyes as well. She has a history of low blood pressure, but she does have high cholesterol.
VISUAL ACUITY: OD 20/60
|
|

55 degree fa mid. od512 viewssimilar photo to autofluorescence
|
|

Retinal Arterial Macroaneurysm - Untreated Hypertension (250/135) - Serous Macular Detachment508 views82 year old asian woman. VA 20/80 Headaches and vision loss for 1 month. Negative medical history but has not been to the doctor for years. (no insurance)
|
|

Retinal Arterial Macroaneurysm - Untreated Hypertension (250/135) - Serous Macular Detachment506 views82 year old asian woman. VA 20/80 Headaches and vision loss for 1 month. Negative medical history but has not been to the doctor for years. (no insurance)
|
|

Self Sealed Retinal Arteriol Macroaneurysm506 viewsMAP shows edema and some subretinal fluid
|
|

Ruptured Retinal Arterial Macroaneurysm - Submacular Hemorrhage - Vision 20/400 never recovered - Hypertension 205/94504 views
|
|

Self Sealed Retinal Arteriol Macroaneurysm - one month after presentation - edema nearly gone504 viewsSD OCT line scan
|
|

Self Sealed Retinal Arteriol Macroaneurysm - MAP shows decreased swelling500 viewsSD OCT map
|
|

Ruptured Retinal Arterial Macroaneurysm - Submacular Hemorrhage - Vision 20/400 never recovered - Hypertension 205/94484 views
|
|

Retinal Arterial Macroaneurysm - Ruptured and self-sealed after hemorrhage480 views90-year-old woman has vision loss in the right eye for 6 weeks. OD 8/200, OS 20/50. Initial Visit
|
|

Self Sealed Retinal Arteriol Macroaneurysm469 viewsFA on presentation showed minimal to no active leakage. Also, there is a small cuff of blood around the MA which is favorable for closure
|
|
Self Sealed Retinal Arteriol Macroaneurysm468 viewsSD OCT line scan with intraretinal fluid
|
|

Self Sealed Retinal Arteriol Macroaneurysm456 viewsSD OCT line scan with intraretinal fluid
|
|

Self Sealed Retinal Arteriol Macroaneurysm452 viewsIR image shows MA on presentation
|
|

Retinal Arterial Macroaneurysm - Ruptured and self-sealed after hemorrhage448 views90-year-old woman has vision loss in the right eye for 6 weeks. OD 8/200, OS 20/50. Initial Visit
|
|

Macroaneurysm - Macular Hemorrhage - Branch Retinal Aterial Occlusion434 views62 year old African American female with chronic hypertension and vision loss for 2 weeks. VA is 20/400
|
|

Self Sealed Retinal Arteriol Macroaneurysm433 viewsFA on presentation showed minimal to no active leakage. Also, there is a small cuff of blood around the MA which is favorable for closure
|
|

Self Sealed Retinal Arteriol Macroaneurysm- one month after presentation - edema nearly gone430 viewsSD OCT line scan
|
|

Macroaneurysm - Macular Hemorrhage - Branch Retinal Aterial Occlusion429 views62 year old African American female with chronic hypertension and vision loss for 2 weeks. VA is 20/400
|
|
Macroaneurysm - Resolved without treatment424 views87 year old female with vision loss OD. Initial FA showed no leakage so no treatment was done and the fluid absorbed over 4 months. Initial VA 20/100, Final VA 20/80
|
|

Self Sealed Retinal Arteriol Macroaneurysm420 viewsFA on presentation showed minimal to no active leakage. Also, there is a small cuff of blood around the MA which is favorable for closure
|
|

Macroaneurysm - Macular Hemorrhage - Branch Retinal Aterial Occlusion419 views62 year old African American female with chronic hypertension and vision loss for 2 weeks. VA is 20/400
|
|

Macroaneurysm - Resolved without treatment417 views87 year old female with vision loss OD. Initial FA showed no leakage so no treatment was done and the fluid absorbed over 4 months. Initial VA 20/100, Final VA 20/80
|
|

Ruptured Retinal Arterial Macroaneurysm - Submacular Hemorrhage - Vision 20/400 never recovered - Hypertension 205/94415 views
|
|

Macroaneurysm - Resolved without treatment415 views87 year old female with vision loss OD. Initial FA showed no leakage so no treatment was done and the fluid absorbed over 4 months. Initial VA 20/100, Final VA 20/80
|
|
|
|